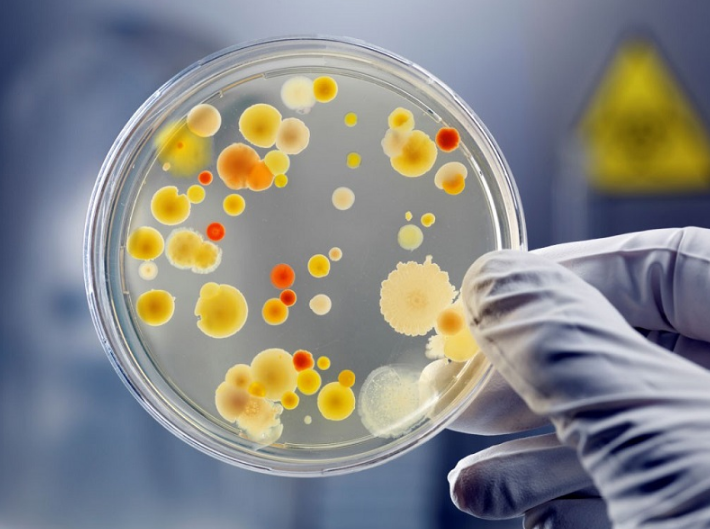
Xét nghiệm sinh học phân tử ở đâu? 2

Dược sĩ Đại học có nhiều năm kinh nghiệm trong việc tư vấn Dược phẩm và hỗ trợ giải đáp thắc mắc về Bệnh học. Hiện đang là giảng viên cho Dược sĩ tại Nhà thuốc Long Châu.
Ngọc Trang
23/04/2024
Mặc định
Lớn hơn
Xét nghiệm sinh học phân tử được sử dụng để giúp các bác sĩ tìm ra nguyên nhân gây bệnh chính xác ở mức độ phân tử, từ đó, có phương án điều trị bệnh hiệu quả hơn. Nhưng vấn đề được nhiều người quan tâm là xét nghiệm sinh học phân tử ở đâu thì uy tín và loại hình xét nghiệm này là gì?
Xét nghiệm sinh học phân tử, một trong những kỹ thuật xét nghiệm hiện đại, đang được ứng dụng phổ biến trong y học ngày nay. Các bác sĩ thường ứng dụng phương pháp này phổ biến trong chẩn đoán các bệnh lý như HIV, HBV,... qua việc thực hiện HBV đo tải hệ thống tự động, HBV đo tải lượng Real-time PCR,... Nhưng thực hiện xét nghiệm sinh học phân tử ở đâu thì đảm bảo chất lượng?
Trước khi tìm hiểu vấn đề nên xét nghiệm sinh học phân tử ở đâu, bạn nên hiểu rõ phương pháp này là gì. Xét nghiệm sinh học phân tử ra đời vào cuối thế kỷ XX dựa trên phương pháp khuếch đại chuỗi PCR tạo ra các phản ứng PCR nhằm nhận diện và định lượng các yếu tố gây bệnh. Nói cách khác xét nghiệm sinh học phân tử chính là hình thức phát hiện các chỉ thị sinh học ở mức độ phân tử.
Loại xét nghiệm này được đánh giá là một trong những bước tiến lớn của nền y học hiện đại, nhất là kỹ thuật giải trình và nhận dạng gen. Kết quả của loại xét nghiệm này cho phép các bác sĩ tìm ra chính xác nguyên nhân gây bệnh và định hướng phác đồ điều trị phù hợp, làm tăng hiệu quả điều trị bệnh.

Cần có những thành phần như sau để thực hiện xét nghiệm sinh học phân tử:
Xét nghiệm sinh học phân tử sử dụng chủ yếu một số kỹ thuật sau:
Các bác sĩ có thể nhận diện được những loại vi khuẩn đang tồn tại trong mẫu xét nghiệm nhờ có phản ứng PCR. Mỗi phản ứng PCR thường ở trong khoảng 20 đến 25 vòng. Số lượng ADN sẽ được khuếch đại với hệ số mũ sau khi kết thúc số vòng.
Để có được kết quả chính xác, mẫu bệnh phẩm được sử dụng cần có nồng độ thích hợp và mỗi giai đoạn cần đảm bảo điều kiện nhiệt độ thích hợp. Trường hợp có sai sót nào thì phản ứng PCR có thể không xảy ra hoặc nếu xảy ra thì hiệu suất thấp hơn so với những dự tính trước đó. Đây chính là nguyên nhân gây ra kết quả âm tính giả.
Về bản chất, kỹ thuật này cũng tương tự với kỹ thuật PCR. Điểm khác biệt là khi sử dụng kỹ thuật này, bác sĩ sẽ dùng một loại thiết bị có thể lưu lại những tín hiệu có được do phản ứng tổng hợp PCR của mẫu xuất hiện. Có thể tính được nồng độ ADN của mẫu thử khi so sánh và đánh giá số vòng của mẫu bệnh phẩm và số phòng đạt được trong thời gian nhất định.
Đây là kỹ thuật tách nhỏ các đoạn ADN/ARN nhờ sự khác nhau về khối lượng và điện tích. Khi được đặt trong một điện trường, các phân tử acid nucleic có thể di chuyển. Những phân tử với kích thước nhỏ sẽ di chuyển nhanh trong khi những phân tử với kích thước lớn sẽ di chuyển chậm. Điện di sẽ được thực hiện trên giấy hay trên gel.
Xét nghiệm sinh học phân tử có những ưu điểm vượt trội nhưng vẫn tồn tại một số điểm hạn chế như sau:

Các xét nghiệm sinh học phân tử được ứng dụng trong chẩn đoán HBV để làm HBV đo tải lượng hệ thống tự động: Giúp nhận diện vi khuẩn HBV cũng như xác định số lượng virus trước khi điều trị, do đó trong suốt quá trình điều trị có thể theo dõi số lượng của virus, đánh giá được sự biến động tăng giảm để có thể xử lý kịp thời.
HBV đo tải lượng Real-time PCR giúp chẩn đoán tình trạng cũng như giai đoạn của bệnh chính xác hơn và sự phát triển của các yếu tố gây bệnh, có ích cho việc điều trị.
Xét nghiệm sinh học phân tử còn góp phần vào việc xác định khả năng kháng thuốc của người bị viêm gan B mạn tính.
Để chẩn đoán HIV, xét nghiệm sinh học phân tử được dùng để làm HIV đo tải lượng hệ thống tự động giúp chẩn đoán định lượng số lượng virus đang có trong cơ thể, từ đó chẩn đoán chính xác để đưa ra phương án điều trị tối ưu nhất và giúp tiên lượng bệnh.
Với các phương pháp xét nghiệm vi sinh cổ điển, không thể xác định hoặc đáp ứng chậm các vi sinh gây bệnh khác nhau đặc biệt là các chủng mới như HIV, HCV, SARS,... hay chỉ là các chủng nấm để có thể chẩn đoán chính xác kịp thời. Nhưng phương pháp xét nghiệm sinh học phân tử lại có thể thực hiện được, giúp chẩn đoán nhanh chóng, chính xác và giúp mang lại hiệu quả điều trị cao.
Người ta cũng sử dụng xét nghiệm sinh học phân tử để chẩn đoán các bệnh lý khác như viêm gan virus C, bệnh lý do nấm chlamydia, do dengue virus, adenovirus hay mycoplasma,... với kỹ thuật tổng hợp PCR và kỹ thuật Real-time PCR để chẩn đoán.

Nhiều bệnh nhân thắc mắc xét nghiệm sinh học phân tử ở đâu thì đảm bảo. Do đây là kỹ thuật rất hiện đại, đòi hỏi bác sĩ thực hiện phải có chuyên môn cao và dày dặn kinh nghiệm, được thực hiện trên những hệ thống thiết bị công nghệ cao và chi phí thực hiện cũng khá tốn kém. Do đó, bác sĩ chỉ định xét nghiệm sinh học phân tử trong trường hợp các phương pháp kỹ thuật xét nghiệm cổ điển không đáp ứng việc điều trị, không thể đưa ra chẩn đoán chính xác cho phía người bệnh. Nếu đã quyết định thực hiện kỹ thuật này, bạn nên lựa chọn những cơ sở y tế đáng tin cậy, uy tín, đảm bảo chất lượng dịch vụ xét nghiệm đạt yêu cầu.
Tóm lại, xét nghiệm sinh học phân tử là thành công lớn của y học, đặc biệt là kỹ thuật giải trình - nhận dạng gen, giúp phát hiện sớm và chính xác nguyên nhân gây bệnh nhằm nâng cao hiệu quả điều trị. Khi thắc mắc xét nghiệm sinh học phân tử ở đâu thì tốt, bạn nên tìm hiểu mọi thông tin về nơi sẽ thực hiện xét nghiệm để đảm bảo kết quả chính xác.
Xem thêm: Xét nghiệm ADN ở bệnh viện nào tốt và uy tín tại TP.HCM
Dược sĩ Đại họcNguyễn Mỹ Huyền
Dược sĩ Đại học có nhiều năm kinh nghiệm trong việc tư vấn Dược phẩm và hỗ trợ giải đáp thắc mắc về Bệnh học. Hiện đang là giảng viên cho Dược sĩ tại Nhà thuốc Long Châu.